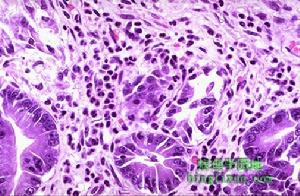
食管賁門黏膜撕裂綜合症

概述
 食管賁門黏膜撕裂綜合症
食管賁門黏膜撕裂綜合症病因
 食管賁門黏膜撕裂綜合症
食管賁門黏膜撕裂綜合症生理
 食管賁門黏膜撕裂綜合症
食管賁門黏膜撕裂綜合症診斷
 食管賁門黏膜撕裂綜合症
食管賁門黏膜撕裂綜合症2.輔助檢查
(1)胃鏡。
(2)食管吞鋇。
(3)動脈造影。本病合併大出血時,血中紅細胞總數及血紅蛋白總量降低。
其他輔助檢查:
1.胃鏡檢查是診斷該病的最有效手段,列為首選,胃鏡應在出血24h內或在出血即時進行。胃鏡下可見食管與胃交界處或食管遠端、賁門黏膜的縱行撕裂,撕裂多為單發,少數為多發,裂傷一般長3~20mm,寬2~3mm。胃鏡下可將裂傷出血分為5類:①活動性動脈性噴血;②活動性血管滲血;③可見血管顯露;④裂傷處黏附有新鮮血痂;⑤單純性裂傷。
2.鋇劑檢查對該病診斷價值較小,僅少數表現在食管壁和胃內鋇劑填充,檢出率較低。
3.動脈造影可經股動脈選擇性插管至胃左動脈,觀察胃左動脈及其食管支動脈,活動性出血者可見造影劑外溢現象,且出血速度須達到0.5ml/min以上。
治療
食管賁門黏膜撕裂綜合症
食管賁門黏膜撕裂綜合症(1)積極補充血容量:保證充足的靜脈通道,必要時輸血,需保持血細胞比容(Hct)在30%以上,血紅蛋白濃度在70g/L以上。但應避免輸血及輸液量過多引起急性肺水腫或再出血。
(2)藥物止血:抑制胃酸分泌:只有當胃內pH>6.0以上時,才能有效的形成血小板聚集及血液凝固,所以須快速提升胃內pH,通常靜脈給予制酸劑,H2受體阻滯藥(如西咪替丁、法莫替丁等),質子泵抑制劑(如奧美拉唑等,目前臨床上多採用後者。加強黏膜保護,可口服硫糖鋁、雙八面體蒙脫石(思密達),複方谷氨醯胺(麥滋林)等;靜脈使用止血類藥物:氨基己酸(6-氨基己酸)、氨甲苯酸(止血芳酸)、血凝酶(立止血)、垂體加壓素等;口服止血藥物:0.8%去甲腎上腺素生理鹽水溶液、凝血酶等。
(3)止嘔:嘔吐劇烈者可以給予止嘔藥如:甲氧氯普胺(胃復安),嗎丁林,莫沙比利等藥物。大多數食管賁門黏膜撕裂出血患者經藥物治療完全可以治癒。
2.內鏡治療隨著內鏡技術的發展,治療內鏡技術在消化道出血緊急止血中起著非常重要的作用,對出血量大,活動性出血或內鏡發現有近期出血的患者都應進行內鏡止血治療。
(1)局部噴灑止血術:其機制是利用局部噴灑藥物收縮血管或在創面形成收斂膜以達到止血的目的。主要用於活動性滲出性出血,尤其適用於撕裂較表淺者。常用藥物:
①0.8%去甲腎上腺素生理鹽水溶液,每次可噴灑20~40ml,有高血壓者慎用,同時注意監測血壓。
②凝血酶,濃度為5000U/40ml。
③孟氏液,即鹼式硫酸亞鐵,濃度為5%~10%,用量大時,可出現腹痛和嘔吐等不良反應。在內鏡下見到活動性滲出性出血後,用生理鹽水先沖洗病灶表面滲出血塊,直視下向出血灶噴灑止血藥物。該方法止血效果確切,安全,副作用小,操作簡便。
(2)注射止血術:其機制是通過向撕裂邊緣或出血點注射藥物,以壓迫、收縮血管或通過局部凝血作用達到止血目
 食管賁門黏膜撕裂綜合症
食管賁門黏膜撕裂綜合症①高滲鹽水-腎上腺素(HSE),由3%氯化鈉液9ml與1:1000腎上腺素1ml配製而成,每點注射0.5~2ml,總量為5~10ml。
②1:10000腎上腺素1ml,1:1000腎上腺素加生理鹽水至10ml,每點注射0.5~1ml,總量不超過10ml。
③1%聚多卡醇,總量不超過5ml。
④其他:15%~20%高滲鹽水、生理鹽水、95%~100%無水乙醇、凝血酶等也可選用。
在內鏡直視下,先用生理鹽水沖洗撕裂創面滲血,從活檢道插入注射針,沿撕裂黏膜的邊緣逐點注射或直接在出血點處注射止血。Josep等對63例食管賁門黏膜撕裂綜合徵隨機分為兩組,一組行內鏡下先注射1∶10000腎上腺素,繼之以1%聚多卡醇注射,而另一組給予傳統治療,結果顯示注射止血術能有效地止血,並且能降低再出血率,減少住院時間及輸血量,但不能降低病死率。Yen和Ramon等研究也顯示注射止血術能成功治療急性嚴重活動性出血。注射止血術操作簡便,療效確切,費用低廉。但要注意併發症的發生,如食管穿孔、食管賁門狹窄、高血壓、心率失常等,故不宜反覆注射,應嚴格控制注射藥物的濃度,同時應注意監測血壓、心率等。
(3)金屬鈦夾止血術:該方法是近年來國內外廣泛開展的一種有效的內鏡止血術。其基本方法是在內鏡直視下,利用金屬止血夾,直接將出血血管或撕裂的黏膜夾持住,起到機械壓迫止血及縫合作用,能達到立即止血及預防再出血的目的。主要適用於有活動性及再出血跡象的撕裂患者。Yasuharu等對26例食管賁門黏膜撕裂征患者放置了金屬鈦夾,平均放置了2.8±1.6個,療效確切,無再出血及併發症的發生,內鏡隨訪未發現金屬夾造成組織損傷和撕裂。Shih組的研究報導有1例患者發生再出血,再次放置止血夾後出血停止,長期隨訪未發現再出血。該方法止血率高,安全,操作簡便,組織損傷小,併發症少,僅個別報導有穿孔發生。鈦夾通常在1~3周自行脫落,隨糞便排出體外。
(4)微波止血術:微波治療可使組織中的極性離子在瞬間發生局部高速震盪,從而產生高溫,使蛋白凝固,達到止血的目的。在內鏡下將微波電極緊貼出血處行固化治療,選擇功率為30~50W,通電時間5~8s,輻射後病變處出現白色凝固斑或呈棕黑色,可多點輻射,直到出血停止。楊毅軍等報導微波治療一次治療止血率達100%,隨訪3個月,患者無繼發症狀出現,也未見瘢痕性賁門狹窄。該方法操作簡便,療效確切,不影響撕裂黏膜癒合。但由於食管沒有漿膜層,撕裂的部位較薄,不宜反覆操作,以防透壁性損傷和穿孔。
(5)其他:電凝止血術,該方法是利用高頻電流通過人體產生熱效應,使組織凝固,從而止血。方法與微波止血術相似。電凝止血術療效可達80%~90%,其併發症主要有穿孔和出血,在操作時電凝強度不能過高,通電時間不能太長,術後給予口服腸道抗生素、止血藥及黏膜保護劑等,24h內禁食。其他還有熱探頭止血術、雷射光凝治療等,其基本原理均為使局部產生高溫,達到組織凝固止血目的。
3.動脈栓塞治療對於經保守治療和內鏡治療失敗的患者,可考慮行動脈栓塞治療,食管賁門部主要由胃左動脈供血,可栓塞胃左動脈或其食管支。採用Seldinger技術經股動脈穿刺插管,選擇性將導管插至胃左動脈,先進行常規血管造影,觀察胃左動脈及其食管支的情況,如發現造影劑外溢,則確診血管破裂出血,使用1mm×1mm×1mm大小的吸收性明膠海綿顆粒進行栓塞止血,然後再行造影觀察栓塞效果。吸收性明膠海綿約2周內吸收。該方法止血迅速可靠,但需要有經驗的介入醫師操作。
預防
 食管賁門黏膜撕裂綜合症
食管賁門黏膜撕裂綜合症劇烈咳嗽、用力排便、舉重、分娩、喘息狀態、癲癇發作等等引起腹內壓力或胃內壓力驟然升高是產生本病的基本原因。因此預防腹內壓力或胃內壓力驟然升高是關鍵。此種撕裂可認為是食管自發性破裂的一種類型。它占上消化道出血原因的2.7%~14.7%。隨著診斷技術的提高,在上消化道出血病因中所占的比例逐漸上升。據20世紀60年代的統計,平均為5.5%,而70年代則上升為8.0%。至於未合併出血的Mallory-Weiss撕裂的發病率如何,現在還不清楚。男性多於女性,發病年齡高峰在30~50歲之間。
